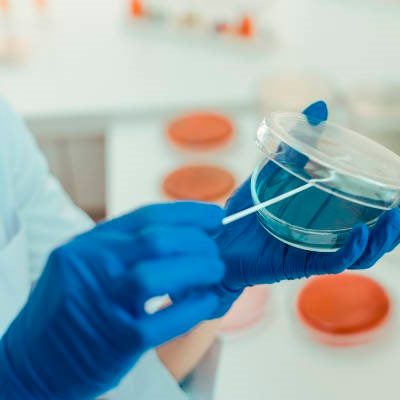

Análisis clínicos
El Centro Médico La Maquinista en colaboración con el prestigioso laboratorio Durán Bellido realizamos todo tipo de análisis clínicos. Trabajamos con la mayoría de las Mutuas y también de modo privado con los mejores precios del mercado.
Disponibilidad los 365 días al año al mejor precio, sin listas de espera, con la máxima fiabilidad y confianza, poniendo la tecnología más innovadora a tu servicio a precios reducidos. Laboratorios centrales de referencia con sistemas de calidad implantados (ISO-9001).
Un equipo de profesionales con muchos años de experiencia trabajando para aportar soluciones, y siempre con un compromiso de calidad y precisión. A través de la combinación de la mejor investigación, los métodos y procesos más optimizados, y unos servicios de atención al paciente rigurosamente validados, aseguramos pruebas de la mejor calidad y fiabilidad, trabajando sólo con los laboratorios que cumplen con los mejores estándares.
Y seguimos trabajando cada día para incorporar los servicios de nuevos laboratorios con el mismo nivel de excelencia, de cara a ofrecer una mayor cobertura presencial por todo el territorio español.
¿Tienes alguna duda? Contacta con nosotros a través de WhatsappVENTAJAS
El mejor precio
Trabajamos con los mejores laboratorios de forma directa para poderte ofrecer los precios más competitivos y asequibles, así de sencillo. Nunca negociamos con la calidad de servicio ni la mermamos, todo lo contrario, la exigimos para formar parte de A365 y así poderte ofrecer la mejor calidad al mejor precio.
Disponibilidad los 365 días del año
Como sabemos que es difícil encontrar el mejor momento disponible, trabajamos con laboratorios clínicos que puedan ofrecerte un servicio de análisis todos los días del año, incluido los festivos. Podrás encontrar muchas de las pruebas con estas facilidades (consulta la página del análisis para confirmarlo, pues su disponibilidad depende de la complejidad de cada uno).
Urgencias analíticas en horas
Si tienes una inquietud, síntoma o necesidad, y quieres realizar un análisis clínico rápido, te facilitamos la mejor solución: contrata directamente tu análisis con uno de nuestros laboratorios, y con un solo clic tendrás la mejor opción para realizar el análisis sin cita previa, sin colas, y te informaremos del reducido tiempo de respuesta con el que trabajamos, obteniendo tus resultados de la forma más ágil posible según cada prueba. Esta agilidad puede ser decisiva para determinar rápidamente un tratamiento o acción.

